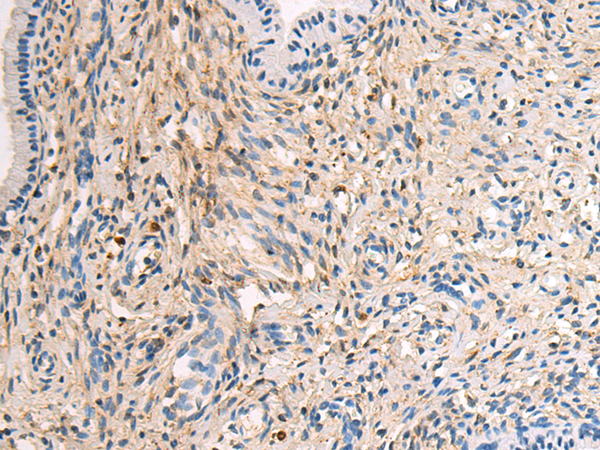

宿 主: Mouse
技術規格
Background:
This gene encodes a secreted ligand of the TGF-beta (transforming growth factor-beta) superfamily of proteins. Ligands of this family bind various TGF-beta receptors leading to recruitment and activation of SMAD family transcription factors that regulate gene expression. The encoded preproprotein is proteolytically processed to generate a latency-associated peptide (LAP) and a mature peptide, and is found in either a latent form composed of a mature peptide homodimer, a LAP homodimer, and a latent TGF-beta binding protein, or in an active form consisting solely of the mature peptide homodimer. The mature peptide may also form heterodimers with other TGFB family members. This encoded protein regulates cell proliferation, differentiation and growth, and can modulate expression and activation of other growth factors including interferon gamma and tumor necrosis factor alpha. This gene is frequently upregulated in tumor cells, and mutations in this gene result in Camurati-Engelmann disease.
Applications:
WB, IHC
Name of antibody:
TGFB1
Immunogen:
Fusion protein of human TGFB1
Full name:
transforming growth factor beta 1
Synonyms:
CED; LAP; DPD1; TGFB; IBDIMDE; TGFbeta; TGF-beta1
SwissProt:
P01137
IHC positive control:
Human cervical cancer and Human thyroid cancer
IHC Recommend dilution:
100-500
WB Predicted band size:
44 kDa
WB Positive control:
Hela cell, NIH/3T3 cell, K562 cell, LNCAP cell, 231 cell lysates
WB Recommended dilution:
1000-5000

購物車
幫助
021-54845833/15800441009
